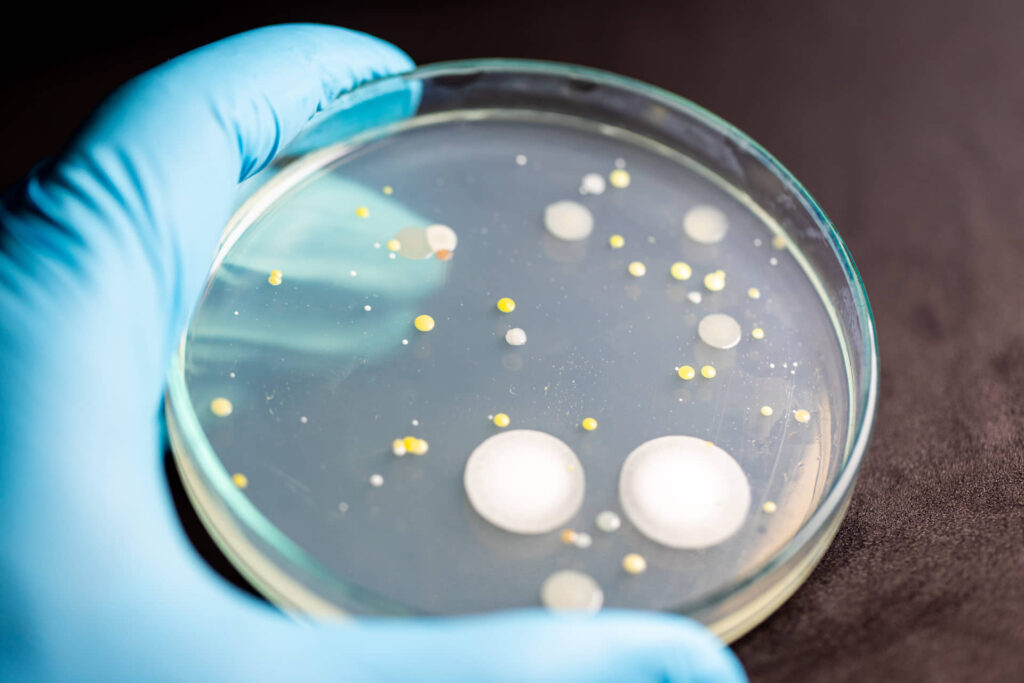
Bacteria in a petri dish

Understanding Hard Water
Effects on Hair and Skin
Hard water, characterized by high levels of calcium and magnesium, can have noticeable effects on both hair and skin. Homeowners who experience issues like dry, itchy skin or dull and brittle hair often find hard water to be the culprit. This section dives into how hard water impacts your personal care routine.
Effects on Hair
When washing hair with hard water, the high mineral content combines with shampoo to create a residue that coats the hair. This residue can block conditioning treatments, resulting in dry and brittle hair. Over time, this can lead to hair breakage. People with sensitive scalps or conditions like eczema or psoriasis may experience additional irritation, which can potentially lead to hair loss (Healthline) (Hair Club).
| Condition | Impact |
|---|---|
| Dryness | Hard water strips natural oils, causing hair to become parched and fragile. |
| Brittleness | Mineral buildup leaves hair stiff and more prone to breakage. |
| Hair Loss | In severe cases, persistent use of hard water can exacerbate conditions like eczema or psoriasis, leading to hair thinning or loss. |
Effects on Skin
Hard water can also negatively impact the skin. The minerals in hard water prevent soap from lathering properly, leading to soap scum that clogs pores and irritates the skin. This often results in dry, stiff, and itchy skin. For individuals with eczema or psoriasis, hard water can aggravate these conditions, making the skin more sensitive and itchy (EcoWater).
| Skin Condition | Impact |
|---|---|
| Dry and Itchy Skin | The minerals in hard water strip away natural oils, causing dryness and itchiness. |
| Acne Breakouts | Soap scum from hard water can clog pores, leading to acne. |
| Eczema and Psoriasis | These conditions can be exacerbated by hard water, making the skin more irritable and sensitive. |
Understanding the effects of hard water is the first step to mitigating its impact. Be mindful of these consequences and explore targeted treatment remedies to maintain healthier hair and skin.
Impact of Hard Water on Hair
When it comes to the effects of hard water on hair, many homeowners are starting to realize the damage it can cause. Let’s take a closer look at some of the research and specific impacts on hair health and color.
Hair Damage Studies
Several studies have pointed to the adverse effects of hard water on hair. One notable 2016 study involving 15 females demonstrated that hard water resulted in decreased hair thickness and a ruffled appearance after washing hair samples in both hard water and distilled water for 30 days.
| Study | Participants | Duration | Findings |
|---|---|---|---|
| 2016 Hair Damage Study | 15 females | 30 days | Decreased hair thickness, ruffled appearance |
Another study including 70 males found that hair lost strength when exposed to hard water, leading to breakage and thinning, which ultimately affects healthy hair growth. Hard water can also negatively impact the scalp, potentially causing hair loss, especially in people with skin conditions like eczema or psoriasis (Healthline).
Effects on Hair Color
Hard water can complicate the work of hair colorists and lead to increased stress on the hair. Hard water leads to a build-up of minerals on the hair, causing new hair color treatments to fade quickly and perms to lose their shape faster (EcoWater). This buildup makes it difficult for color to penetrate evenly, resulting in less vibrant, dull hair.
| Effect | Impact |
|---|---|
| Mineral Buildup | Less effective cleansing, quicker color fade |
| Perm Flattening | Perms lose their shape faster |
| Product Use | Requires more hair products for same results, increasing costs |
Furthermore, the adverse effects on the scalp can exacerbate hair loss, particularly in individuals with eczema or psoriasis (Healthline).
Managing Hard Water Effects
Managing the effects of hard water on hair can be challenging. By using the right treatments, one can maintain healthy and vibrant hair. Below are expert-approved treatments and DIY solutions for tackling hard water hair woes.
Recommended Hair Treatments
- Water Softener Shower Head: Installing a water softener shower head can help reduce the mineral content in water, thus minimizing its harsh effects on hair.
- Clarifying Shampoos:
Clarifying shampoos remove mineral buildup caused by hard water. They are essential for those experiencing dullness or heaviness in their hair. Notable shampoos include:
- Oribe’s The Cleanse Clarifying Shampoo
- Malibu C Hard Water Wellness Shampoo
- Ouai’s Detox Shampoo
- Living Proof Perfect Hair Day Triple Detox Shampoo
- Olaplex No. 4 Bond Maintenance ShampooThese shampoos contain chelating and clarifying ingredients like EDTA, charcoal, vitamin C, or apple cider vinegar, which effectively remove mineral deposits (Self).
- Nourishing Hair Masks:
Applying a nourishing hair mask at least twice a week can help restore moisture and repair the hair cuticle. This is especially beneficial after using clarifying shampoos, as they can sometimes contribute to dryness. - Citrus and Vinegar Rinse:
A rinse made from citrus juice or vinegar can help lower the hair’s pH, making it smoother and shinier. This rinse, rich in hair-healthy vitamins, effectively removes mineral residues.
DIY Solutions
- Apple Cider Vinegar Rinse:
Mixing equal parts of apple cider vinegar and water creates an effective rinse that can remove mineral buildup. Use this rinse once a week after shampooing. - Lemon Juice Rinse:
A mixture of lemon juice and water can help to break down and wash away the mineral deposits on the hair shaft. Apply this rinse after shampooing, leave it on for a few minutes, and then rinse it out. - Baking Soda Paste:
Baking soda can be used to counteract hard water effects. Mix a tablespoon of baking soda with enough water to create a paste. Apply it to the hair, leave for a few minutes, and then rinse thoroughly.
| DIY Treatment | Ingredients | Instructions |
|---|---|---|
| Apple Cider Vinegar Rinse | Apple cider vinegar, Water | Mix equal parts vinegar and water. Rinse after shampooing. |
| Lemon Juice Rinse | Lemon juice, Water | Mix 1 part lemon juice to 2 parts water. Apply, leave for 3-5 minutes, rinse. |
| Baking Soda Paste | Baking soda, Water | Mix 1 tbsp baking soda with water to form a paste. Apply, leave for a few minutes, rinse. |
By incorporating these treatments, homeowners can effectively manage the hard water effects on their hair.
Common Signs of Hard Water
Identifying hard water in your home can save you from a world of hair and skin issues. Here, we’ll guide you on recognizing the tell-tale signs and how to test for water hardness.
Recognizing the Issue
Hard water is notorious for leaving visible and tangible signs around the house. Here are some key indicators:
- Mineral Deposits: White or chalky residues on faucets, fixtures, and shower doors are a clear sign of hard water. This buildup is due to high levels of calcium carbonate.
- Spotty Dishes: After using the dishwasher, you may notice white spots or a cloudy film on glassware and dishes.
- Stiff and Faded Laundry: Clothes and towels may feel rough and appear faded after washing.
- Reduced Water Flow: Mineral deposits can clog pipes and faucets, leading to decreased water pressure.
- Soap Scum: Hard water prevents soap from lathering properly, leaving a sticky residue on skin and in tubs.
Testing Water Hardness
Testing water hardness is essential to confirm your suspicions about hard water. Here’s how to do it:
Home Test Kits
Simple home test kits are available and easy to use.
- Collect a Water Sample: Fill a clean container with water from the tap.
- Dip the Test Strip: Follow the instructions on the kit. Typically, you’ll dip a test strip into the water for a few seconds.
- Compare Colors: The strip will change color based on the hardness. Compare it with the provided chart to determine the hardness level.
Water Hardness Levels
| Hardness Level | mg/L (ppm) | Grains per Gallon (gpg) |
|---|---|---|
| Soft | 0 – 60 | 0 – 3.5 |
| Moderately Hard | 61 – 120 | 3.5 – 7.0 |
| Hard | 121 – 180 | 7.0 – 10.5 |
| Very Hard | 181+ | 10.5+ |
Figures sourced from Culligan.
Professional Testing
For a more accurate assessment, consider professional testing. Companies like Portasoft offer comprehensive water analysis services. The experts at Portasoft can pinpoint the exact hardness levels, providing valuable insights for tackling the problem.
Solutions for Hard Water
When dealing with hard water and its effects on hair, it’s important to look into viable solutions that can mitigate or completely eliminate the issue. Here, we discuss two main categories: water softeners and hair care products.
Water Softeners
Water softeners offer a comprehensive solution to hard water problems by removing the minerals that cause hardness, such as calcium and magnesium. This not only benefits your hair but also has a positive impact on your skin and household appliances. Here’s a quick overview of how water softeners can help:
| Feature | Benefit |
|---|---|
| Removes Minerals | Eliminates calcium and magnesium from water, preventing hair dryness and scalp irritation |
| Improves Hair Health | Ensures better absorption of shampoos and conditioners, resulting in softer, more manageable hair |
| Reduces Residue | Prevents mineral residue buildup on hair, which can block conditioning treatments (Hair Club) |
Installing a water softener can be a worthwhile investment, and it’s particularly recommended for homeowners who experience multiple signs of hard water.
Hair Care Products
Using specialized hair care products can also help manage the effects of hard water on your hair. These products are designed to counteract the negative impact of mineral deposits and improve your hair’s overall health. Here are some options:
| Product | Function |
|---|---|
| Clarifying Shampoos | Contain surfactants like sulfates or chelating agents such as EDTA, charcoal, vitamin C, or apple cider vinegar to remove mineral buildup. Use sparingly, no more than twice a month, to avoid dryness (Self) |
| Nourishing Conditioners | Helps restore moisture and repair the hair cuticle. It’s recommended to use these regularly, especially after clarifying shampoos |
| Hair Masks | Weekly treatments can deeply condition and rejuvenate dry, brittle hair (Self) |
Recommended Products
Below is a list of recommended products available in the market for treating hard water hair issues:
| Product Name | Description |
|---|---|
| XYZ Shampoo | A clarifying shampoo best used twice a month |
| ABC Conditioner | A nourishing conditioner suitable for daily use |
| DEF Hair Mask | A weekly hair mask packed with moisturizing ingredients |
For homeowners dealing with hard water, combining a water softener with specific hair care products can offer a balanced solution, ensuring that hair remains healthy and manageable.
Preventing Hard Water Damage
Hard water can wreak havoc on hair, leaving it dry, brittle, and difficult to manage. Fortunately, there are ways to mitigate these effects. Two effective strategies involve using shower filters and implementing specific maintenance tips.
Shower Filters
Shower head water filters can make a significant difference in preventing hard water damage. These filters work by stripping minerals and chlorine out of the water before it touches the hair (Hair Club). This can help reduce mineral buildup, which leads to dryness and frizz.
Benefits of Shower Filters:
- Removes harsh minerals like calcium and magnesium.
- Reduces chlorine content, which can strip natural oils.
- Minimizes buildup on the scalp and hair strands.
Here’s a simple comparison of the effectiveness of different shower filters:
| Type of Filter | Average Mineral Removal (%) | Cost Range |
|---|---|---|
| Basic Carbon Filter | 60 – 70% | $20 – $50 |
| Vitamin C Filter | 70 – 80% | $30 – $60 |
| Multi-Stage Filter | 80 – 95% | $50 – $100 |
Maintenance Tips
Proper maintenance of your hair care routine can also help counteract the negative effects of hard water.
Weekly Routine:
- Clarifying Shampoo: Use a clarifying shampoo once a week to remove mineral buildup on the scalp and hair (Healthline). This ensures that any residue from hard water does not accumulate over time.
- Nourishing Hair Mask: Apply a nourishing hair mask at least twice a week. This helps in hydrating and strengthening hair weakened by hard water.
Daily Care:
- Sulfate-Free Shampoos: Use sulfate-free shampoos to maintain the natural oils in your hair. This can help in reducing the dryness caused by the minerals in hard water.
- Cold Water Rinse: After washing, rinse your hair with cold water to seal the cuticles, which can help in reducing frizz and increasing shine.
- Focus on Scalp: Concentrate on cleaning the scalp to avoid unnecessary exposure of the hair lengths to hard water minerals (Healthline).
Additional Tips:
- Citrus and Vinegar Rinse: A citrus and vinegar rinse lowers the hair’s pH and contains hair-healthy vitamins. This can be done by mixing one cup of water with a few drops of lemon juice or vinegar and applying it to the hair after shampooing.
- Pre-Shampoo Treatments: Pre-shampoo treatments can provide a protective barrier against the minerals in hard water, reducing the overall damage (Culligan).
Invest in Soft Water, Invest in Your Well-being
Addressing hard water is more than just a cosmetic concern; it’s an investment in the long-term health and comfort of your hair and skin. By taking proactive steps to soften your water, you’re not only addressing current issues but also preventing future damage and ensuring a more enjoyable and effective personal care routine for years to come. Contact Portasoft to learn how a water softener can transform your home water and your daily life.